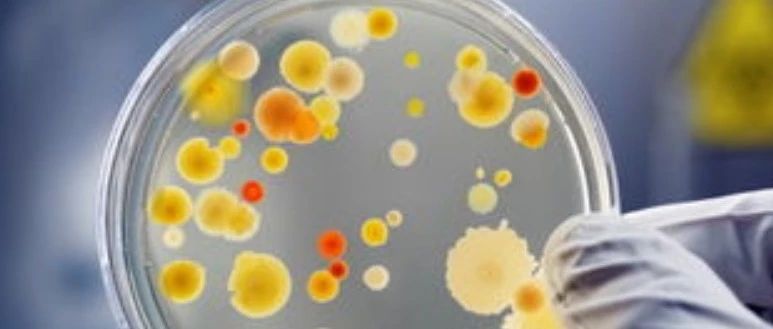

CLSI直通车
-
 第 4 卷,第 1 期,2019 年 1 月第一部分翻译:宁永忠 北京垂杨柳医院审稿:时黎明 山东省菏泽市立CLSI直通车2019-02-03 21:32 宁永忠
第 4 卷,第 1 期,2019 年 1 月第一部分翻译:宁永忠 北京垂杨柳医院审稿:时黎明 山东省菏泽市立CLSI直通车2019-02-03 21:32 宁永忠 -
 第 4 卷,第 1 期,2019 年 1 月第三部分翻译:黄磊(北京大学第一医院)审稿:宁永忠(垂杨柳医院)CLSI直通车2019-02-03 21:32 宁永忠
第 4 卷,第 1 期,2019 年 1 月第三部分翻译:黄磊(北京大学第一医院)审稿:宁永忠(垂杨柳医院)CLSI直通车2019-02-03 21:32 宁永忠 -
 表H3. 分子方法检测肠杆菌科ESBL和碳青霉烯酶的结果报告(前半部分)CLSI直通车2019-01-24 00:00
表H3. 分子方法检测肠杆菌科ESBL和碳青霉烯酶的结果报告(前半部分)CLSI直通车2019-01-24 00:00 -
附录表H2. 分子和表型药敏试验方法检测肠球菌属万古霉素耐药的结果报告CLSI直通车2019-01-22 21:01
附录表H2. 分子和表型药敏试验方法检测肠球菌属万古霉素耐药的结果报告CLSI直通车2019-01-22 21:01 -
 抗微生物药物的耐药性和敏感性很复杂,现在已经有体外试验方法可以预测微生物对体内抗细菌治疗的反应。CLSI直通车2019-01-19 23:03
抗微生物药物的耐药性和敏感性很复杂,现在已经有体外试验方法可以预测微生物对体内抗细菌治疗的反应。CLSI直通车2019-01-19 23:03 -
 Antimicrobial Susceptibility Testing (AST) of Infrequently Isolated or Fastidious Bacteria..and the CLSI M45 GuidelineCLSI直通车2018-12-02 17:18 Janet Hindler
Antimicrobial Susceptibility Testing (AST) of Infrequently Isolated or Fastidious Bacteria..and the CLSI M45 GuidelineCLSI直通车2018-12-02 17:18 Janet Hindler -

-


